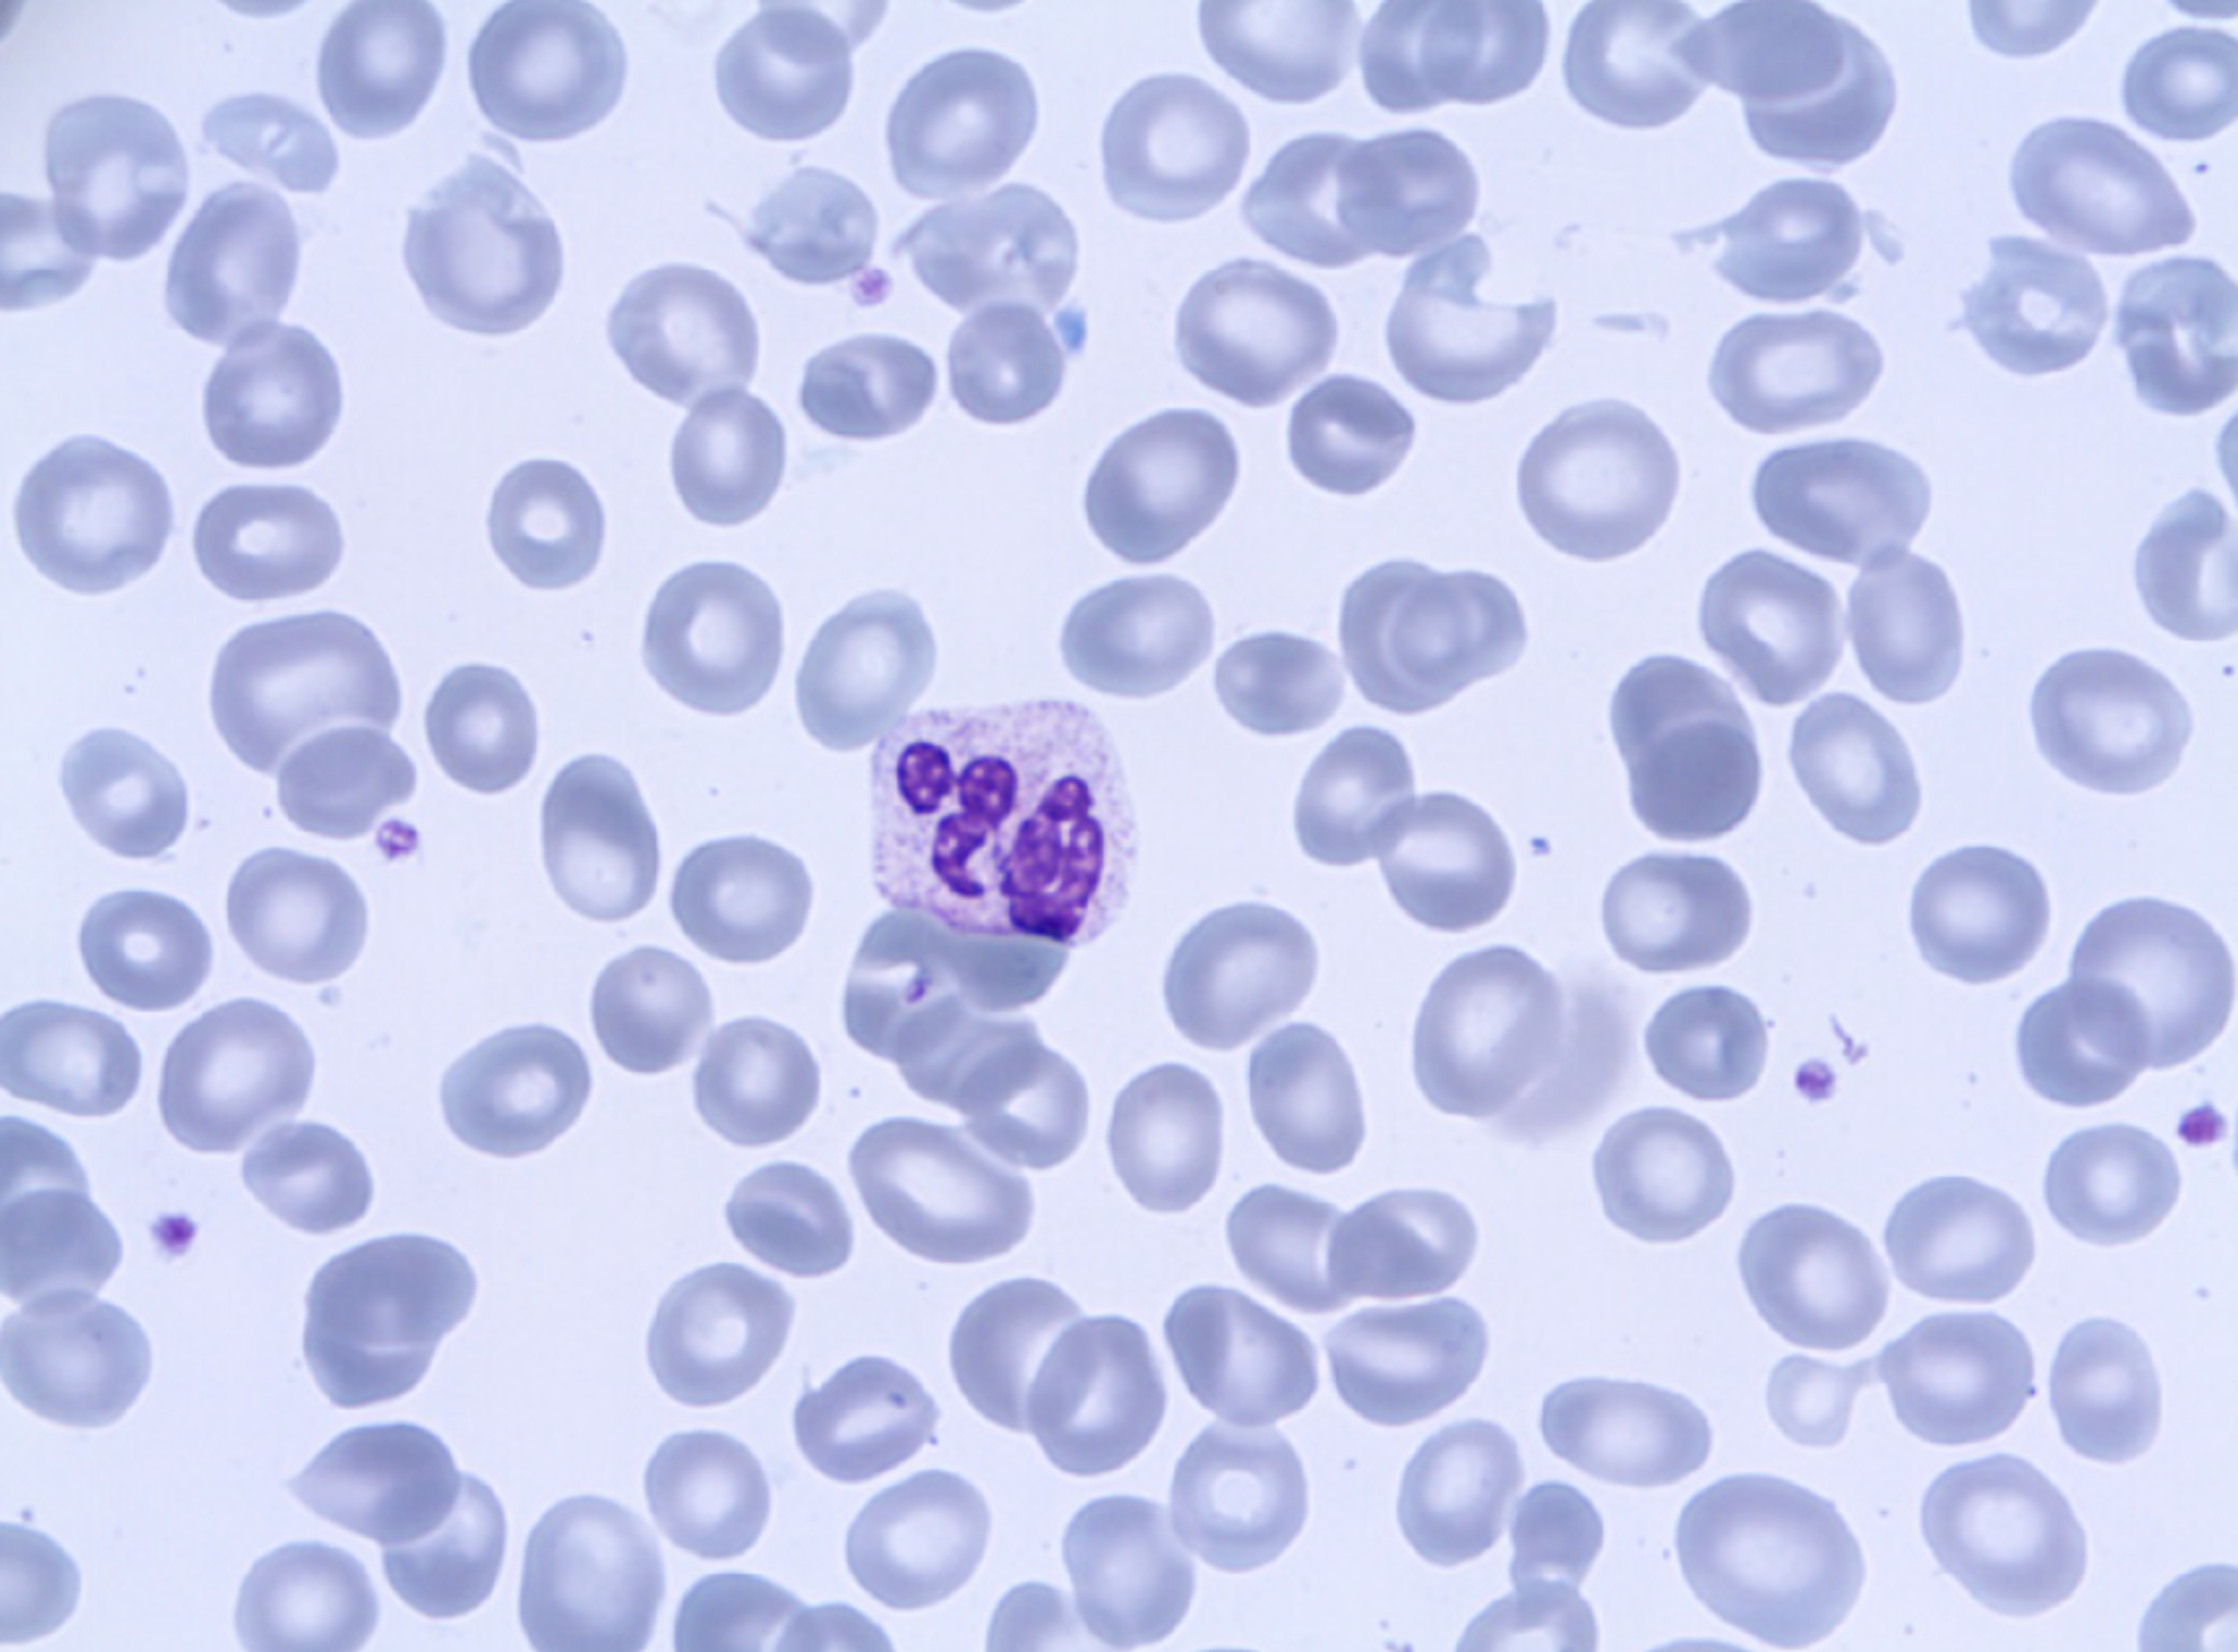

Resources
25
Selected Filters:
Product Brochures
Overcome bottlenecks in NGS panel reporting
Product Brochures
Veya: Effortless automation
Application Note
Develop and deliver your IVD with confidence
Product Brochures
KT Premium Slides: Results you can trust
Product Brochures
High Capacity Slide Dryer Brochure
Product Brochures
PiSmart Cassette Printer Brochure
Product Brochures
PiSmart Slide Printer Brochure
Product Brochures
KT Koverglass Brochure
Product Brochures
Find premium comfort in your manual pipettes
Scientific Poster
Assessing adhesion slide performance across histology applications
Product Brochures
Pipetting techniques for accurate results
Product Brochures
Redefining rapid AST for Gram-negative bloodstream infections
Product Brochures
2024 World Sepsis Congress Spotlight PDF Program
Infographic
Decoding the host response to infection
Application Note
Rapid phenotypic AST for Gram-negative bacteria
Application Note
PAT-enabled scaling and optimization of upstream bioprocesses
Application Note
Automated size selection of NGS libraries for HLA diagnostics
Application Note